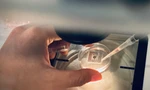
Miễn phí thụ tinh trong ống nghiệm cho 100 cặp vợ chồng khó khăn, hiếm muộn

Ngày 30/12/2022, Bộ Chính trị ban hành Nghị quyết số 31-NQ/TW về phương hướng, nhiệm vụ phát triển TPHCM đến năm 2030, tầm nhìn đến năm 2045, Nghị quyết tạo thêm động lực cho TPHCM phát triển mạnh mẽ, toàn diện. Riêng đối với Ngành y tế, Nghị quyết nêu rõ “Xây dựng hệ thống y tế tiên tiến, hiện đại, ứng dụng kỹ thuật, công nghệ cao, phát triển một số lĩnh vực tiếp cận trình độ công nghệ thế giới, hướng tới mục tiêu là trung tâm chăm sóc sức khoẻ khu vực ASEAN”.
Trên thực tế, hệ thống y tế công lập và tư nhân tại TPHCM những năm qua đang phát triển mạnh mẽ, đáp ứng ngày càng tốt hơn nhu cầu chăm sóc sức khỏe của người dân trong nước và các nước lân cận. TS.BS Nguyễn Anh Dũng, Phó giám đốc Sở Y tế TPHCM cho biết, sau thành công của Hội nghị: “Đánh giá hiệu quả và định hướng phát triển y tế chuyên sâu tại TPHCM” (ngày 17/6/2023) những cơ sở khoa học để xây dựng Đề án phát triển y tế chuyên sâu tại thành phố đã được định hình cho giai đoạn từ nay đến năm 2025 và những năm tiếp theo.
 |
| TS.BS Nguyễn Anh Dũng, Phó giám đốc Sở Y tế TPHCM |
Theo đó, 7 nhóm giải pháp đang được tập trung thực hiện gồm: (1)Hình thành trung tâm đào tạo nhân lực y tế chất lượng cao; (2) Phát triển cơ sở hạ tầng hiện đại, triển khai khu y tế kỹ thuật cao theo mô hình viện trường; (3) Giải pháp phát triển kỹ thuật chuyên sâu đáp ứng mô hình bệnh tật và nhu cầu chăm sóc sức khỏe của người dân; (4) Giải pháp xây dựng mạng lưới chăm sóc theo chuyên khoa từ y tế chuyên sâu đến y tế cơ sở; (5) Giải pháp cung ứng đầy đủ các loại hình chăm sóc sức khỏe có chất lượng, đáp ứng nhu cầu đa dạng của người dân; (6) Giải pháp để TPHCM trở thành điểm đến du lịch y tế, đẩy mạnh kết hợp y học hiện đại và y học cổ truyền; (7) Giải pháp đẩy mạnh hoạt động nghiên cứu và phát triển (R&D) và hoạt động đổi mới sáng tạo trong lĩnh vực y tế.
Bên cạnh đó, Sở Y tế cũng đề xuất lãnh đạo thành phố về phương án hình thành 3 cụm y tế khi xây dựng đề án phát triển TPHCM trở thành trung tâm chăm sóc sức khoẻ của khu vực ASEAN theo tinh thần chỉ đạo của Nghị quyết số 31-NQ/TW.
Các cụm y tế được đề xuất bao gồm: “Cụm y tế trung tâm” với hệ thống các bệnh viện đa khoa, chuyên khoa tuyến cuối hiện hữu trên địa bàn các quận trung tâm của thành phố, tiếp tục giữ vai trò chủ lực trong phát triển y tế chuyên sâu; “Cụm y tế Tân Kiên” đang trên lộ trình hiện thực hoá thành những cơ sở y tế chuyên sâu với cơ sở hạ tầng hiện đại, hướng đến trong tương lai không xa giữ vai trò chủ lực trong phát triển y tế vùng các tỉnh đồng bằng sông Cửu long; Cụm thứ ba là “Cụm y tế Thủ Đức” khi hình thành sẽ đóng vai trò quan trọng trong việc hỗ trợ, phát triển y tế vùng Đông Nam bộ.
 |
| TPHCM sẽ phát triển loại hình cấp cứu đường hàng không và đường thủy trong thời gian tới |
Cùng với chiến lược thúc đẩy hoạt động đào tạo nguồn nhân lực y tế chất lượng cao, ngành y tế thành phố đang chủ trương xây dựng mạng lưới cấp cứu ngoại viện theo hướng chuyên nghiệp, hiện đại. Ngoài mô hình cấp cứu đường bộ đang triển khai, thời gian tới, loại hình cấp cứu đường hàng không, đường thủy sẽ được đẩy mạnh để ứng phó kịp thời với mọi tình huống khẩn cấp.
TS.BS Nguyễn Anh Dũng cho biết, ngành y tế đang xây dựng và triển khai hàng loạt đề án nâng cao chất lượng khám chữa bệnh như: Đề án y tế thông minh; hình thành trung tâm tầm soát, chẩn đoán bệnh sớm bằng công nghệ cao; phát triển công nghiệp dược... Cùng với đề án thực hiện tự chủ tài chính và các chính sách đặc thù giúp các bệnh viện công lập phát triển bền vững, ngành y tế đang xúc tiến thực hiện đề án huy động các nguồn lực xã hội đầu tư phát triển y tế TPHCM giai đoạn 2023-2025 và những năm tiếp theo.
Nội dung trên là những tóm lược của bài tham luận “Phát triển y tế chuyên sâu tại TPHCM” sẽ được TS.BS Nguyễn Anh Dũng trình bày trong Hội thảo “Giải pháp hướng tới mục tiêu trở thành Trung tâm chăm sóc sức khỏe Khu vực ASEAN” do Bộ Y tế phối hợp với Báo Tiền Phong và các đơn vị liên quan tổ chức vào sáng 19/10.
Hội thảo sẽ được chia thành 2 phiên chuyên đề, phiên chuyên đề 1: Phát triển y tế chuyên sâu chăm sóc người bệnh trong nước và quốc tế; phiên chuyên đề 2: Sẵn sàng cho mục tiêu trở thành trung tâm chăm sóc sức khỏe khu vực ASEAN với các diễn giả đến từ Bộ Y tế, các Sở Y tế, bệnh viện và các trường đạo tạo sức khỏe. Hội thảo diễn ra trực tiếp tại Trường ĐH Quốc tế Hồng Bàng (số 215 đường Điện Biên Phủ, P.25, Q. Bình Thạnh, TPHCM) và trực tuyến trên các nền tảng số của báo Tiền Phong cùng các đối tác phối hợp tổ chức.